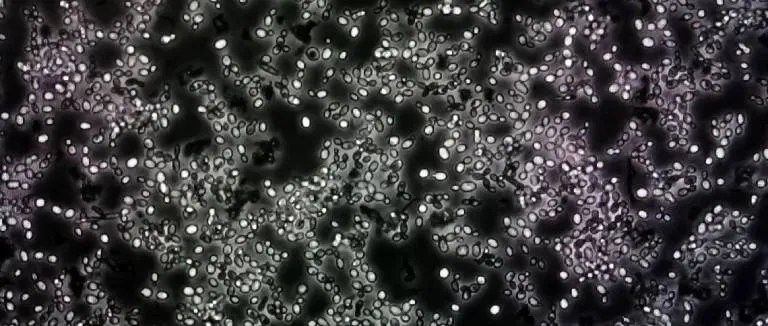
Pamukçuğa Ne İyi Gelir?

Pamukçuk Nedir? Neden Olur? Pamukçuğa Ne İyi Gelir?
Son Güncelleme Tarihi 3.03.2026 12:41:55
Pamukçuk, candida albicans adlı mantarın neden olduğu bir enfeksiyondur. Bu mantar normalde ağızda, bağırsaklarda ve vajinada oluşum gösterir. Bununla birlikte bazı durumlarda mantar aşırı büyüme göstererek pamukçuk oluşumuna neden olabilir.

Pamukçuk Nedir?
Pamukçuk genellikle ağızda, dilde, yanaklarda, diş etlerinde, damakta ve boğazda beyaz, sevimsiz lekeler olarak görülür. Bu lekeler ağrı, yanma, kaşıntı, kötü tat ve yutma güçlüğüne neden olabilir. Pamukçuk her yaşta ortaya çıkabilir. Bununla birlikte bebeklerde, yaşlılarda, hamilelerde, şeker hastalarında, kanser hastalarında ve antibiyotik kullananlarda da ortaya çıkabilir. Bu durum genellikle antifungal ilaçlarla tedavi edilir. Ayrıca ağız hijyeni sağlamak, şekerli ve işlenmiş gıdalardan kaçınmak, probiyotik almak ve bağışıklığı artırmak pamukçukun önlenmesine ve tedavisine yardımcı olabilir.
Bebeklerde Pamukçuk Neden Olur?
Bebeklerde pamukçuk genellikle enfeksiyona neden olan mantarının anneden bebeğe bulaşmasından veya bebeğin olgunlaşmamış bağışıklık sisteminden kaynaklanabilir. Bebekler doğum sırasında annenin vajinasından geçerken veya emzirme sırasında annenin göğsünü emerken pamukçuk mantarı ile enfekte olabilir. Ayrıca bebeğin ağzını temizlememek, biberon ve emziği sterilize etmemek veya bebekte sindirim sistemi hastalıkları olması pamukçuk oluşumuna yol açabilir.
Bebeklerde Pamukçuk Belirtileri Nelerdir?
Bebeklerde pamukçuk sonucunda ağızda beyaz lekeler, beslenmeyi reddetme, huzursuzluk, ağlama ve kilo kaybı gibi belirtiler ortaya çıkabilir. Bu durum antifungal ilaçlar veya evde uygulanabilecek bazı doğal yöntemlerle tedavi edilebilir. Doğal tedavi yöntemleri arasında ağzı karbonatlı su, hindistan cevizi yağı, yoğurt, sarımsak, elma sirkesi ve kefir ile temizlemek yer alabilir. Pamukçuk ve aft ağız içinde benzer belirtiler gösterebilir. Bu nedenle doğru ayrım için aft nedir sorusunun yanıtı önemlidir.

Dilde Pamukçuk Neden Olur?
Pamukçuk, ağız içindeki dokularda mantar enfeksiyonu gelişmesi sonucu oluşan bir hastalıktır . Pamukçuk özellikle dilin üstünde, yanakların içinde ve damakta süt parçalarını andıran beyaz lezyonlar şeklinde görülür. Dildeki candida albicans mantarının aşırı büyümesi sonucunda bu bölgede pamukçuk oluşabilir. Bu mantar normalde ağızda yaşar ve bağışıklık sistemi tarafından kontrol altında tutulur. Ancak bağışıklık sisteminin zayıflaması, antibiyotik kullanımı, diyabet, kanser, HIV, AIDS, hamilelik, ağız kuruluğu, ağız hijyeninin kötü olması, takma diş kullanımı, sigara ve alkol tüketimi mantarın aşırı büyümesine ve pamukçuğa neden olabilir. Dildeki pamukçuk dil üzerinde beyaz kazınmış lekeler olarak görülebilir. Bu lekeler ağrı, yanma, kaşıntı, kötü tat, tat bozukluğu ve yutma güçlüğüne neden olabilir.
Pamukçuğa Ne İyi Gelir?
Pamukçuk, doktor tarafından reçete edilen antifungal ilaçlarla tedavi edilebilir. Ancak ilaç tedavisine ek olarak veya herhangi bir tıbbi yönteme başvurmadan önce evde uygulanabilecek bazı doğal yöntemler de pamukçuk iyileşmesine katkı sağlayabilir. Pamukçuk tedavisinde kullanılan doğal yöntemlerden bazıları şu şekildedir:
- Kabartma Tozu Suyu: Kabartma tozu, mantarın büyümesini önleyen alkali bir ortam yaratır. Bir bardak ılık suya bir çay kaşığı kabartma tozu eklenerek oluşturulan karışımla ağzı çalkalamak pamukçuk iyileşmesine katkı sağlayabilir.
- Tuzlu Su: Tuz, mantarın büyümesini önleyen ve enfeksiyonu iyileştiren antiseptik bir etkiye sahiptir. Tuzlu su ile gargara yapmak pamukçuk tedavisinde etkili bir yöntem olabilir.
- Hindistan Cevizi Yağı: Hindistan cevizi yağı mantara karşı etkili antifungal ve antimikrobiyal bir yağdır. Etkilenen bölgeye hindistan cevizi yağı uygulamak pamukçuk iyileşmesine katkı sağlayabilir. pamuklu bir ped kullanın.
- Yoğurt: Yoğurt, mantarın büyümesini engelleyen ve ağızdaki asit-baz dengesini düzenleyen probiyotik bir besindir. Düzenli yoğurt tüketimi pamukçuk oluşumunu önlemeye yardımcı olabilir.
- Sarımsak: Sarımsak mantara karşı güçlü bir bileşik olan allicin içerir. Sarımsakları ezip etkilenen bölgeye uygulamak veya günde birkaç diş sarımsak tüketmek pamukçuk tedavisinde etkili olabilir. Bununla birlikte kontrolsüz sarımsak tüketimi istenmeyen etkilerin oluşmasına neden olabilir. Bu nedenle sarımsak tüketiminde dikkatli olmak oldukça önemlidir.
- Elma Sirkesi: Elma sirkesi mantarın büyümesini önleyen ve bağışıklık sistemini güçlendiren asetik asit ve enzimler içerir. Bir bardak ılık suya iki yemek kaşığı elma sirkesi eklemek ve bu karışımla ağzı çalkalamak ağız bölgesinde oluşan pamukçukların tedavi edilmesinde oldukça önemlidir.
- Kefir: Kefir mantarın büyümesini engelleyen ve ağızdaki asit-baz dengesini düzenleyen probiyotik bir içecektir. Düzenli kefir tüketimi pamukçuk oluşumunu önlemeye yardımcı olabilir.
Vajinal Pamukçuk Nedir?
Vajinal pamukçuk vajinadaki candida albicans mantarının aşırı büyümesinin neden olduğu bir enfeksiyondur. Vajinal pamukçuk genellikle kaşıntı, yanma, ağrı, kızarıklık, şişme, beyaz akıntı, cinsel ilişki sırasında ağrı ve idrara çıkma gibi semptomlara neden olur. Vajinal pamukçuk antibiyotik kullanımı, diyabet, hamilelik, hormonal değişiklikler, kötü hijyen, dar giysiler, cinsel ilişki ve stres gibi faktörler sonucunda oluşum gösterebilir. Bu durum antifungal ilaçlar veya evde uygulanabilecek bazı doğal yöntemlerle tedavi edilebilir.
Sıkça Sorulan Sorular
Mantar enfeksiyonu ile enfekte olmak sonucunda yetişkinlerde pamukçuk ortaya çıkabilir. Bu duruma neden olan faktörlerden bazıları şu şekildedir:
- Bağışıklık Sisteminin Zayıflaması: Kanser, HIV, AIDS, organ nakli veya bazı ilaçların kullanılması sonucunda bağışıklık sistemi zayıflayabilir. Bağışıklık sisteminin zayıflaması pamukçuk oluşumuna yol açabilir.
- Diyabet: Yüksek şeker seviyeleri candida mantarının büyümesi ve ağızda pamukçuk oluşmasına neden olabilir.
- İlaçlar: Kortikosteroidler, antibiyotikler veya doğum kontrol hapları gibi bazı ilaçlar ağızdaki mikroorganizmaların dengesini değiştirebilir. Bu durum sonucunda yetişkinlerde pamukçuk oluşumu ortaya çıkabilir.
- Bazı Ağız Rahatsızlıkları: Takma diş kullanan, ağız kuruluğu yaşayan veya ağız mukozasını etkileyen başka ağız sorunları olan kişilerde ağız bölgesinde pamukçuk oluşabilir.
Pamukçuk, candida albicans adlı bir mantarın ağızda aşırı çoğalması sonucu oluşan bir enfeksiyondur. Bu mantar normalde ağızda bulunur ve diğer bakteriler tarafından kontrol altında tutulur. Ancak bazı durumlarda bu denge bozulur ve mantar aşırı çoğalarak pamukçuk hastalığına yol açar. Pamukçuk genellikle ağızda, dilde, yanaklarda, diş etlerinde, damakta ve boğazda beyaz renkli, peynirimsi tabakalar şeklinde görülür. Pamukçuk genellikle antifungal ilaçlarla tedavi edilir. Ayrıca ağız hijyenine dikkat etmek, şekerli ve işlenmiş gıdalardan uzak durmak, probiyotik almak ve bağışıklığı güçlendirmek de pamukçuk önlemede ve tedavisinde etkili olabilir.
Bebeklerin ağzında pamukçuk oluşumu yetişkinlere benzer bir şekilde ortaya çıkabilir. Bebeklerin bağışıklık sistemi henüz tam gelişmediği için ağızda bulunan candida albicans mantarının büyümesini kontrol edemeyebilir. Bu durum sonucunda bebeklerde pamukçuk oluşumu gözlenebilir. Bununla birlikte bebeklerin ağzı neden pamukçuk olur? sorusunun farklı cevapları da bulunabilir. Bebeklere doğum sırasında veya emzirme esnasında annelerinden pamukçuk bulaşabilir. Bebeklerde pamukçuk ağızda beyaz ve peynirimsi lekeler, emmeyi reddetme, huzursuzluk ve kilo kaybı gibi belirtilerle kendini gösterebilir.